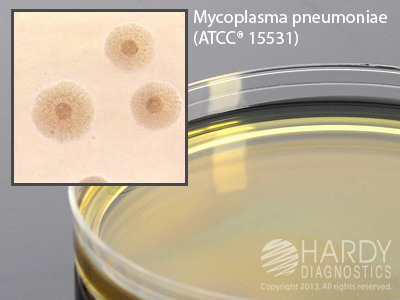
PPLO Selective Agar

Details
- Manufacturer: Hardy
- Mfr. Cat. # G105
- Brand Name: Hardy
Microbiology » Culture Media Plates
PPLO Selective Agar
Medix Item Code: HPS-G105
$141.55 per Pack
List Price: $165.87
You Save: $24.32 (15%)
Size: Pack of 10
Features
- For the selective isolation of Mycoplasmataceae especially Mycoplasma pneumoniae.
Description
PPLO Selective Agar, for Mycoplasma pneumoniae, 18ml, 15x100mm plate, order by the package of 10. For the selective isolation of Mycoplasmataceae (pleural pneumonia-like organisms), especially Mycoplasma pneumoniae.